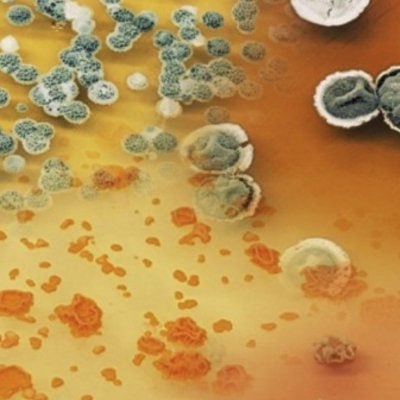
professor profile picture

Ben Shen
Professor
University of Florida
United States
Has open position
This profile is automatically generated from trusted academic sources.
Google Scholar
.
ORCID
.

How do Pakistani students reach out?
Sign in for free to see their profile details and contact information.
Meet Kite AI
Contact this professor
Research Interests
Biocatalysis
10%
Natural Product
10%
Chemistry
10%
Chemical Synthesis
10%
Bacteria
10%
Ask ApplyKite AI
Start chatting
How can you help me contact this professor?
What are this professor's research interests?
How should I write an email to this professor?

How do Pakistani students reach out?
Sign in for free to see their profile details and contact information.
Meet Kite AI